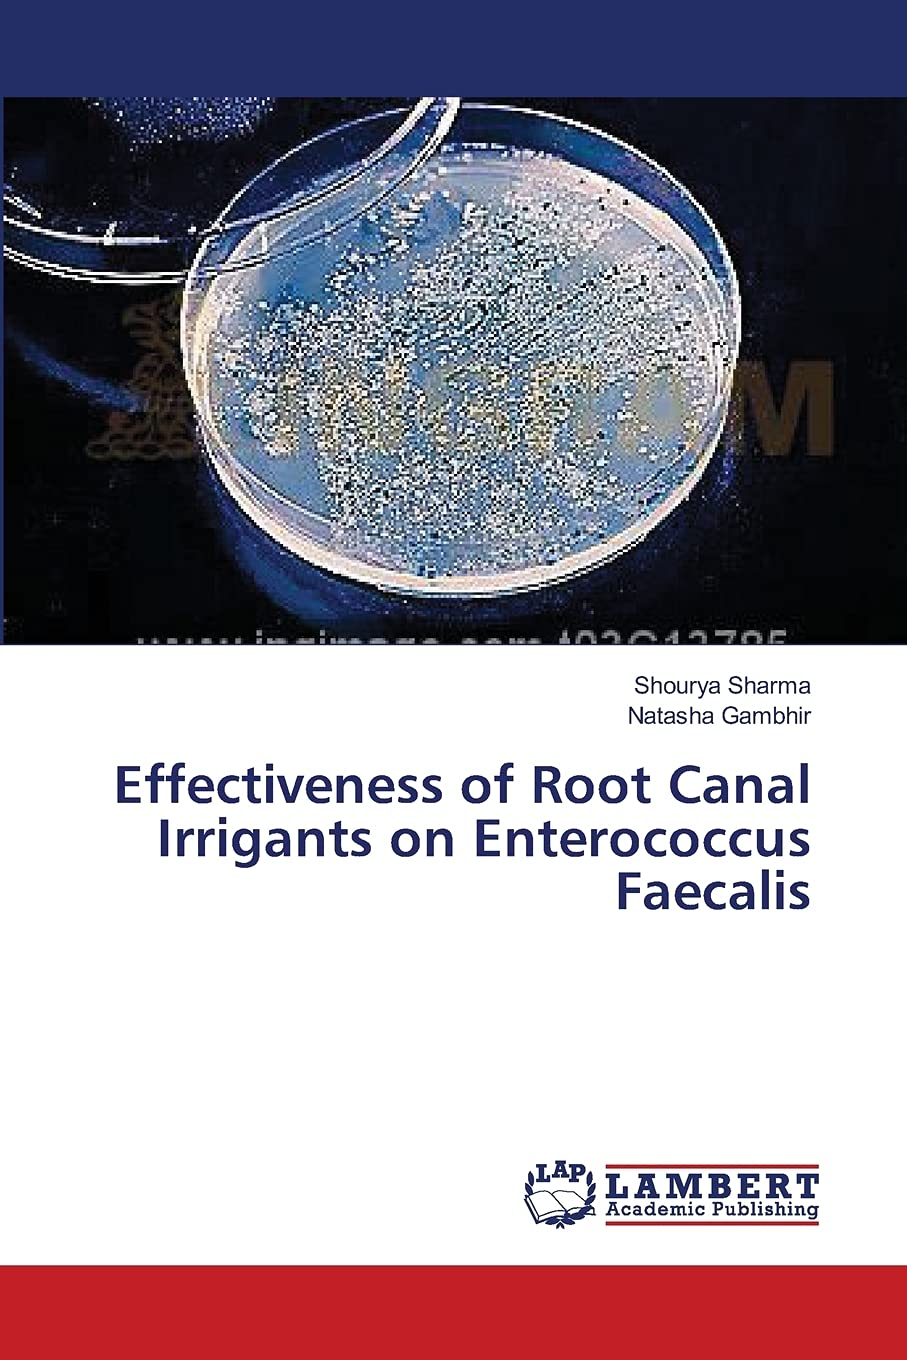
Effectiveness of Root Canal Irrigants on Enterococcus Faecalis

Various factors have been reported which contribute to the failure of root canal treatment. The presence of persistent intraradicular infection due to surviving microorganisms in the root canal is one of them. The positive correlation between bacteria and endodontic disease has been established. Microbial control within pulpal tissue and root canal space is a prerequisite for the prevention and treatment of pulpal and periapical breakdown. Therefore, during root canal treatment it is very important to control microbial agents by biomechanical procedures, which can be carried out successfully with the help of irrigating solutions. One of the most popularly researched organisms known to survive in the root canal even after use of strong irrigants is Enterococcus Faecalis. The resilient nature of E. faecalis in endodontic infections is well documented. The primary purpose of this study was to compare the antimicrobial effect of various irrigants against Enterococcus faecalis.
Trustpilot
2 weeks ago
2 weeks ago
4 days ago
2 weeks ago